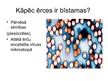

-
Ērces
-
Ērces
VidusskolaPrezentācija19 -
Mitoze
VidusskolaPrezentācija4 -
Pesticīdi
VidusskolaPrezentācija6
Ērces
Faila izmērs:
2877 KB
Identifikators:
1230379